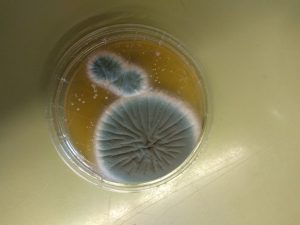

Els alumnes de biologia de primer de batxillerat hem realitzat una pràctica en la qual hem pogut observar fongs i bacteris. Els bacteris són microorganismes, per tant, organismes molt petits, procariotes i unicel·lulars. Consten de paret bacteriana, membrana plasmàtica i ADN bacterià. Els fongs, en canvi, són microorganismes eucariotes.
El més fascinant d’aquesta pràctica ha estat que els bacteris i fongs que hem vist provenen de materials i coses que ens envolten. Per tant, els bacteris que vam observar provenien d’una sola de la sabata, del mànec de la porta, de la mateixa pell, tos i inclús de l’ambient durant una classe.
Alguns dels objectius de la pràctica eren: efectuar correctament una preparació temporal, saber diferenciar virus de bacteris i les seves característiques, saber perquè serveixen les plaques de cultiu i aprendre a sembrar-ne una, saber esterilitzar la zona de treball i els materials necessaris amb el cremador bec Bunsen, saber com i per a què s’utilitza la iogurtera, entre d’altres coses.
El procediment correcte a seguir és:
o Esterilitzar la zona de treball obrint el bec Bunsen.
o Esterilitzar la nansa de sembra passant-la per la flama fins que la punta es torna roja.
o Fregar la nansa a la sola de la sabata i després a la placa de Petri per transferir els bacteris.
o Tapar la placa i posar-la a la iogurtera per fer el cultiu i veure les colònies de bacteris.
o Deixar endollada la iogurtera durant 48 h.
Passades les 48 h anem al laboratori:
o A la placa de Petri podem veure molts puntets. Cada puntet és una colònia de bacteris que consta de milers d’aquests. També s’han format floridures (fongs) causades per la contaminació de la placa de cultiu, en el moment que vam sembrar els bacteris, amb espores.
o Esterilitzar una altra vegada la nansa de sembra i fregar-la als bacteris o fongs de la placa per recollir-ne una mostra.
o En un portaobjectes net posar un parell de gotes d’aigua amb el comptagotes i fregar la nansa de sembra per transferir els bacteris o fongs recollits anteriorment.
o Agafant el portaobjectes amb les pinces de fusta, es passa per la flama (baixa) per fixar la pràctica.
o Col·locar el portaobjectes sobre el vidre de rellotge i tenyir la pràctica amb el tint blau de metilè, només si el que s’ha recollit ha sigut bacteris, amb els fongs no cal.
o Esperar uns minuts i netejar la pràctica amb aigua destil·lada.
o Retirar l’excés d’aigua i col·locar la mostra a la platina del microscopi per poder observar-la.
Fent servir el material correcte i seguint el procediment, vam arribar als resultats i conclusions següents: vam observar puntets de bacteris, que són colònies formades per milers de bacteris. Tots els bacteris que veiem provenen d’un que s’ha reproduït per bipartició. La pràctica observada al microscopi va ser amb una lent ocular de 15x, un objectiu de 10x i un total de 150x.
A partir de les pràctiques realitzades ara sabem que per observar bacteris hem de fer una tinció, que per fer una bona pràctica hem de mantenir la zona esterilitzada i que per fer el cultiu correcte s’ha de deixar la iogurtera endollada 48h aproximadament, mai més temps, ja que si no es començarien a eliminar els bacteris.
1r Batxillerat A